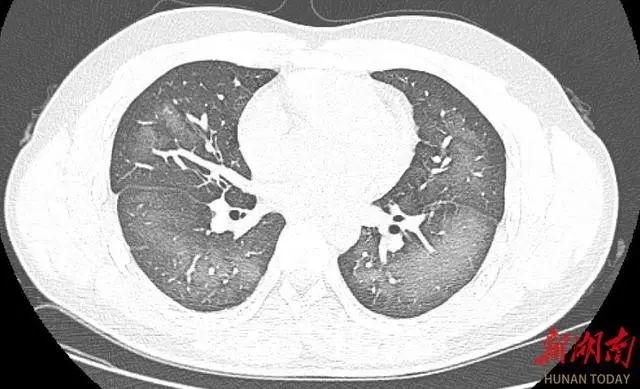

夏日炎炎 正是需要防晒的时候 市场上的防晒产品琳琅满目 其中 使用起来方便又有清凉感的 防晒喷雾 成了近几年的网红产品 不过,近日 湖南长沙一位小伙没想到 因使用防晒喷雾不当 竟给自己带来了不小的麻烦 使用防晒喷雾时误吸 20岁小伙检竟查出“白肺” 日前,20岁的长沙小伙李林(化名)在外出前使用了防晒喷雾,在对着面部喷洒时一不小心误吸,随即出现胸闷、咳嗽的症状。症状一直持续到第二天仍未好转,他急忙来到湖南省长沙市第三医院就诊。 经检查,肺部CT片显示,李林双肺赫然呈现大范围白色样病变,报告提示“白肺”。 “白肺”一般是指重症肺炎在X线或CT检查下的表现,患者肺部呈现一大片的白色状态,往往会出现呼吸困难、呼吸衰竭,严重者还会出现其他脏器功能障碍。 “白肺”常见于高龄(65岁以上)、免疫力低下、有重要器官慢性病史(如心脏病、中风史、慢性肾脏病、慢性阻塞性肺疾病等)、有多种疾病并存(比如既有高血压、糖尿病,又有心脏病、肺病、肾功能不全)等人群。

1.选用温和无刺激、适合自己肤质的产品。如果对酒精不耐受,不要选用含有酒精的防晒喷雾。 2.因个人肤质不同,首次使用前可以把少量防晒喷雾涂抹在耳后、肘关节内侧等部位进行皮试,保持24~72小时,确定无不适反应以后再进行使用。 3.使用防晒喷雾时主要喷洒在身体部位,使用时与皮肤至少保持15~20厘米的距离。使用于面部和颈部时,请先喷洒在手上,然后用手均匀涂抹。若不慎入眼,要立即用水清洗;如有不适要暂停使用。 4.不要在肌肤伤口、红肿或湿疹等有异常的部位使用防晒喷雾。 5.不要在同一个身体部位近距离(如10厘米内)连续喷射超过3秒,防晒喷雾中的推进剂喷出后会迅速挥发吸热,长时间或者近距离使用可能会冻伤皮肤。 6.不要在卫生间、车内等狭小密闭不通风空间内使用,喷洒时要注意通风,使用时紧闭口鼻,勿刻意吸气,避免大量吸入喷雾。 7.应放在儿童接触不到的地方,儿童应在成人监护下使用防晒喷雾。建议给儿童选择配方温和、标识有儿童化妆品标志“小金盾”的防晒产品。 8.防晒喷雾中通常含有易燃物质,请存放在阴凉干燥通风环境中,避免阳光直晒。使用时应远离火源、热源、静电,不得撞击产品,不得将产品或使用完的空罐刺穿或投入火中。
编辑 | 杨丽